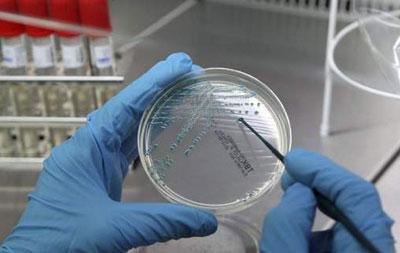
Посев на кишечную палочку

Заражение кишечной палочкой – опасное заболевание, которое требует незамедлительного лечения. В противном случае бактерии распространяются по всему организму и проводят к поражению внутренних органов.
Что представляет собой кишечная палочка
Кишечная палочка – это разновидность бактерий, которые имеют палочковидную форму. Они принадлежат к группе анаэробных факультативных бактерий. Это означает, что
существовать и размножаться они могут исключительно в условиях отсутствия кислорода
.
Кишечная палочка имеет несколько разновидностей. Часть из них относится к разряду непатогенных. Они присутствуют в теле каждого из нас. Роль кишечной палочки в организме человека – стимулировать синтез витамина К и подавлять развитие вредной микрофлоры. Патогенные формы бактерии способны приводить к развитию серьезных заболеваний.
Кишечная палочка существует и размножается при условии температуры окружающей среды на уровне 37 градусов. Она питается в кишечнике минеральными веществами и продуктами распада аминокислот. Сохраняет свою жизнеспособность, попадая в водоемы, почву и продукты. От того, где живет бактерия, будет зависеть способ инфицирования.
Кишечная палочка, или Escherichia coli, является нормальным обитателем кишечника человека и животных, однако некоторые её штаммы могут вызывать серьезные заболевания. Врачи отмечают, что инфекции, вызванные патогенными штаммами, могут проявляться в виде диареи, болей в животе и других симптомов. Основные пути передачи инфекции — это употребление зараженной пищи или воды, а также контакт с инфицированными людьми.
Для профилактики заболеваний, связанных с кишечной палочкой, медики рекомендуют соблюдать правила гигиены: тщательно мыть руки, овощи и фрукты, а также избегать употребления непроверенных продуктов. В случае появления симптомов инфекции важно обратиться к врачу, который может назначить необходимые анализы и лечение. В большинстве случаев инфекции проходят самостоятельно, но в некоторых случаях может потребоваться антибиотикотерапия. Врачи подчеркивают важность своевременной диагностики и лечения для предотвращения осложнений.

Разновидности кишечной палочки
На сегодняшний день выявлено несколько патогенных штаммов этой бактерии. Они способны провоцировать различные заболевания. Выделяют следующие виды кишечных палочек:
- Энтеропатогенные. Чаще всего встречается эта кишечная палочка у ребенка. После попадания на слизистую поверхность кишечника она запускает процесс ее разрушения. Бактерии препятствую нормальному всасыванию питательных веществ в кровь человека. Поражается в первую очередь тонкая кишка.
- Энтеротоксигенная. Бактерии, прикрепившиеся ворсинками к эпителию желудочно-кишечного тракта, выделяют токсины. Они становятся благоприятной средой для развития кишечной палочки.
- Гемолитическая. Эта разновидность бактерии считается самой опасной. Она становится причиной угнетения функций кишечника и желудка. В некоторых случаях ее жизнедеятельность приводит к мышечному параличу внутренних органов.
- Энетроинвазивная. Развитие такой инфекции сопровождается появлением сильных болевых ощущений, кровавой диареи. Если вовремя не принять меры, наступит серьезная стадия обезвоживания организма.
- Энтерогеморрогическая. Эти бактерии за короткое время проникают в клетки тела и вызывают их отмирание. Деятельность такой кишечной палочки приводит к развитию гемморагического колита и поражению почек.
От разновидности бактерии зависит проявление инфекции. Поэтому определить возбудителя часто можно по характерной симптоматике.
Какие болезни провоцирует кишечная палочка
Бактерия кишечная палочка может вызывать несколько различных заболеваний.
Заражение такими микроорганизмами принято называть эшерихиозом
. Проявляется проблема по-разному, в зависимости от локализации очага. Выделяют следующие заболевания, которые провоцируются бактерией:
- В результате активности энтеропатогенной бактерии появляется нарушение работы пищеварительной системы, которое в первую очередь выражается энтероколитом. Такое явление чаще встречается у детей, посещающих детский сад. Инфицирование может произойти и в роддоме или больнице.
- Энтеротоксигенные бактерии вызывают симптомы, аналогичные холере. Заражение происходит путем употребления инфицированной воды и продуктов питания. В некоторых случаях происходит развитие менингита, сепсиса, отита и других осложнений.
- Энтероинвазивные бактерии приводят к появлению инфекции, аналогичной дизентерии. При серьезной степени поражения инфекция поражает мочеполовую систему. Диагностируется цистит у женщин, пиелонефрит, заболевания предстательной железы у мужчин и другие проблемы.
- Энтерогеморрагическая кишечная палочка опасна развитием тяжелых инфекционных заболеваний кишечника у детей. Причем последствия такой болезни могут быть весьма тяжелыми: почечная недостаточность, анемия, падение концентрации тромбоцитов в крови.
- Опасно попадание любых бактерий во влагалище женщины. Это приводит к воспалению половых органов. Вначале появляется вульвовагинит или кольпит. Если вовремя не устранить возбудителя, инфекция поднимается к маточным трубам и матке. Развивается эндометрит. При дальнейшем движении бактерий вверх по организму они попадают в брюшную полость, наблюдается перитонит. Болезнь, вызванная кишечной палочкой, проявляется по-разному и может иметь массу осложнений на органы и системы тела. Поэтому возбудителя необходимо выявить как можно раньше и незамедлительно приступить к лечению.
Кишечная палочка, или Escherichia coli, — это бактерия, обитающая в кишечнике человека и животных. Большинство штаммов безвредны и даже полезны, но некоторые могут вызывать серьезные заболевания. Люди часто обсуждают, как важно поддерживать баланс микрофлоры и избегать инфекций, связанных с патогенными штаммами. Основные источники заражения — недоваренное мясо, непастеризованные молочные продукты и загрязненная вода. Чтобы избежать проблем, важно соблюдать правила гигиены: тщательно мыть руки, готовить пищу при достаточной температуре и избегать контакта с потенциально опасными продуктами. В случае появления симптомов, таких как диарея или боли в животе, следует обратиться к врачу для получения рекомендаций и лечения.

Каким путем можно заразиться
Немаловажный вопрос, как передается кишечная палочка. Только зная пути заражения, можно предотвратить инфицирование. Выделяют следующие способы, как можно заразиться бактерией:
- Контактный. Кишечная палочка передается от человека к человеку. Возбудитель может жить в ротовой полости, на коже, прятаться в царапинах. Поэтому подцепить инфекцию можно даже при простом рукопожатии. Кроме того, бактерии могут некоторое время жить и на бытовых предметах, которыми пользовался зараженный человек.
- Алиментараный. Возбудитель попадает во внешнюю среду посредством дефекации. Он переносится насекомыми на любые предметы. Оттуда и попадает в организм человека, который не соблюдает всех норм гигиены.
- Воздушно-капельный. Заразиться можно даже при разговоре с больным человеком. Слюна, испаряясь, смешивается с воздухом. Радиус такого поражения составляет около трех метров.
Основным источником, откуда берется бактерия, становится человек. Вспышки инфекционных заболеваний характерны для мест большого скопления людей, например, образовательные учреждения, больницы, детские сады.
Контактируя с предметами, зараженный человек инфицирует их. Например, для здорового ребенка опасны игры с теми же игрушками, чтение тех же книг и использование той же мебели, что и больные дети.
Еще одним местом, где обитает кишечная палочка, становится вода. Для того чтобы заболеть, иногда достаточно просто попить воды из крана. Чаще всего такое случается, если пить воду, находясь на отдыхе за границей.
Даже при условии наличия на водопроводе мощной системы фильтрации, пить воду из него не стоит. Некоторые разновидности бактерий могут выживать и в таких условиях.
Причины инфицирования могут крыться и в употреблении некачественных продуктов питания. Особенно опасной становится молочнокислая среда, в которой микроорганизмы могут активно размножаться. Часто бывает заразна еда животного происхождения. Поэтому нельзя есть продукты, которые продавались на рынке в не прикрытом виде, например, колбасные изделия без упаковки.
Основные проявления болезни
Признаки кишечной палочки у взрослых и детей могут различаться в зависимости от разновидности бактерии. Но выделяют и ряд общих симптомов:
- Нарушения стула. Могут происходить запоры или диареи.
- Болевые ощущения в области брюшной полости.
- Зловонный запах изо рта.
- Тошнота и рвотные позывы.
- Каловые массы приобретают нехарактерный запах.
- Человек быстро устает и постоянно чувствует себя сонным.
- Наблюдается резкое снижение аппетита.
- Вздутие живота.
То, как выглядит клиническая картина болезни, зависит от вида бактерий и их локализаций. Исходя из типа кишечной палочки, выделяют симптомы:
- Энтеротоксигенные палочки приводят к некрозу тканей кишечника. Это сопровождается диареей с примесью крови, частыми приступами рвоты, болевыми ощущениями в области живота.
- Энтерогеморрагические бактерии приводят к появлению ярких симптомов интоксикации организма, стул становится водянистым, в нем обнаруживается примесь крови.
- Симптомами энтеропатогенной кишечной палочки становится потеря аппетита, рвотные позывы, дети часто срыгивают, проблемы с засыпанием.
- Энтероинвазивная инфекция проявляется водянистым стулом с примесями крови, болевыми ощущения в нижней части живота, приступами тошноты.
- Гемолизирующая инфекция проявляется примесями крови в кале, кровоизлияниями, которые заметны на кожных покровах, появлением желтухи, снижением уровня гемоглобина.
Первые симптомы заражения кишечной палочкой появляются спустя несколько дней после инфицирования. Если вовремя не принять соответствующие меры, развиваются патологии внутренних органов.

Определение точного диагноза
В домашних условиях достоверно определить наличие и конкретный вид кишечной палочки невозможно.
Для постановки точного диагноза потребуются лабораторные исследования
. Существует несколько методик:
- Бактериоскопическая. У пациента берутся образцы содержимого кишечника, вагинальный мазок, анализ мочи и крови. Все отобранные материалы изучаются под микроскопом.
- Бактериологическая. Отобранный у пациента биологический материал переносится в специальную благоприятную среду. Если кишечная палочка присутствует, то спустя некоторое время она начинает активно размножаться. В некоторых случаях впоследствии может проводиться антибиотикограмма. С ее помощью определяется чувствительность бактерии к различным видам актибактериальных препаратов.
- Если инфекция локализована в кишечнике, то необходимо исследование на определение степени дисбактериоза.
Только после того, как патогенная кишечная палочка обнаружена и определен ее вид, специалист может ставить точный диагноз и разрабатывать методику, как бороться с проблемой.
Особенности лечения
Подход к тому, как лечить кишечную палочку, должен быть комплексным. Терапия должна проводиться под обязательным контролем специалиста. Выделяют следующие особенности правильного лечения:
- Применение антибактериальных препаратов. Для того чтобы терапия прошла максимально успешно, в лабораторных условиях определяют, какие антибиотики убивают кишечную палочку в конкретном случае. С этой целью проводится специализированное исследование. Избавиться от кишечной палочки можно после окончания двухнедельного курса медикаментозного лечения. Спустя два месяца после окончания терапии необходимо провести повторный бактериологический посев для контроля. Если повторно выявляется инфицирование, то курс приема антибиотиков придется повторить. Только так можно будет окончательно убить кишечную палочку. Сколько лечится заболевание, будет зависеть от особенностей организма пациента и степени заражения.
- Терапия осложнений. Если заражение спровоцировало развитие сопутствующих заболеваний, то в программу лечения входят мероприятия по их устранению. Для этих целей применяются соответствующие лекарственные препараты.
- Соблюдение диетического рациона. Вылечить кишечную палочку можно при соблюдении особого режима питания. В меню должно входить больше каш, приготовленных на воде, слизистых супов, отварных овощей, нежирного мяса и рыбы, приготовленных на пару. Категорически запрещено питаться копченостями, жирными и жареными блюдами, консервами, молоком, свежими фруктами, пряностями.
- Когда кишечная инфекция сопровождается сильной рвотой и диареей, происходит обезвоживание организма. Для того чтобы восстановить нормальный баланс, пациенту необходимо пить как можно больше чистой воды. В тяжелых случаях применяются лекарственные препараты, например, регидрон или трисоль. Помимо этого, рекомендуется применять сорбенты с первых же дней болезни. Хороший результат дает лечение энтеросгелем, смектой, полисорбом и другими препаратами этой группы.
- Допускается и лечение народными средствами. Применение рецептов нетрадиционной медицины возможно только совместно с консервативной терапией. Хорошо помогает средство, изготовленное на основе топинамбура. Около 250 грамм очищенных клубней необходимо нашинковать небольшими ломтиками и переложить в ковш. Туда же влить стакан молока и такое же количество воды. Варить топинамбур необходимо до тех пор, пока он не станет полностью мягким. Полученный отвар отфильтровывают. В приготовленную жидкость добавляют немного сливочного масла и муки. Немного уваривают. Таким соусом заливают оставшийся топинамбур и сдабривают свежей зеленью. Такое блюдо можно есть на завтрак или обед. Оно эффективно борется с бактериями и восстанавливает микрофлору кишечника.
Любые народные средства имеют противопоказания. Перед их применением необходимо непременно проконсультироваться с врачом.
Теперь вы знаете, чем лечат кишечную инфекцию. Конкретные препараты и их дозировки подбираются специалистом индивидуально для каждого пациента.
Профилактические действия
Для того чтобы предотвратить заражение кишечной палочкой, необходимо соблюдать простые меры предосторожности. Профилактика включает в себя:
- Соблюдение всех принципов личной гигиены. Старайтесь как можно чаще мыть руки, особенно после пребывания в общественных местах.
- Взрослым, ведущим активную половую жизнь, необходимо помнить о правилах интимной гигиены.
- Не ешьте немытые фрукты и овощи.
- При приготовлении блюд следите за тем, чтобы продукты хорошо проваривались. Не режьте мясо и остальные продукты на одной и той же разделочной доске.
- Все оставшиеся блюда обязательно храните в холодильнике.
- Не пейте воду из водопровода и неизвестных источников. Безбоязненно можно пить только кипяченую воду.
Соблюдая простые правила, можно обезопасить себя от кишечной палочки. Но если заражение все же произошло, нужно как можно быстрее принимать меры.
Вопрос-ответ
Как и чем убить кишечную палочку?
Основа лечения кишечных инфекций в легкой форме – регидратация (восполнение потерянной жидкости тела больного путем приема солевых растворов внутрь) и дезинтоксикационная терапия. Для выведения токсических продуктов возбудителя используются сорбенты, эубиотики, ферменты и вяжущие средств.
Как понять, что у тебя кишечная палочка?
Повышение температуры тела до 37, 5–39 градусов, иногда выше, головная боль, ломота в мышцах, слабость, болевые ощущения, рези в области живота, отказ от употребления еды, тошнота, рвота, диарея (возможно наличие каловых масс с примесью слизи).
Что убивает кишечную палочку в кишечнике?
Единственным эффективным способом уничтожения бактерий STEC в пищевых продуктах является бактерицидная обработка, такая как нагревание (например, тепловая обработка или пастеризация) или облучение.
Какое средство убивает кишечную палочку?
Ципрофлоксацин («Ципринол», «Цифран ОД»). Норфлоксацин («Нормакс», «Норбактин», «Нолицин»). «Офлоксацин».
Советы
СОВЕТ №1
Изучите основные виды кишечной палочки, чтобы понимать, какие из них могут быть опасны для здоровья. Например, штаммы E. coli O157:H7 могут вызывать серьезные заболевания, в то время как другие штаммы являются нормальными обитателями кишечника.
СОВЕТ №2
Соблюдайте правила гигиены при приготовлении пищи. Тщательно мойте руки перед едой и после работы с сырыми продуктами, особенно мясом и овощами, чтобы снизить риск заражения кишечной палочкой.
СОВЕТ №3
Обратите внимание на термическую обработку продуктов. Убедитесь, что мясо и яйца готовятся до безопасной температуры, чтобы уничтожить потенциально опасные бактерии, включая кишечную палочку.
СОВЕТ №4
Если у вас появились симптомы, такие как диарея, боли в животе или лихорадка, обратитесь к врачу. Не занимайтесь самолечением, так как некоторые штаммы кишечной палочки могут требовать специфического лечения.